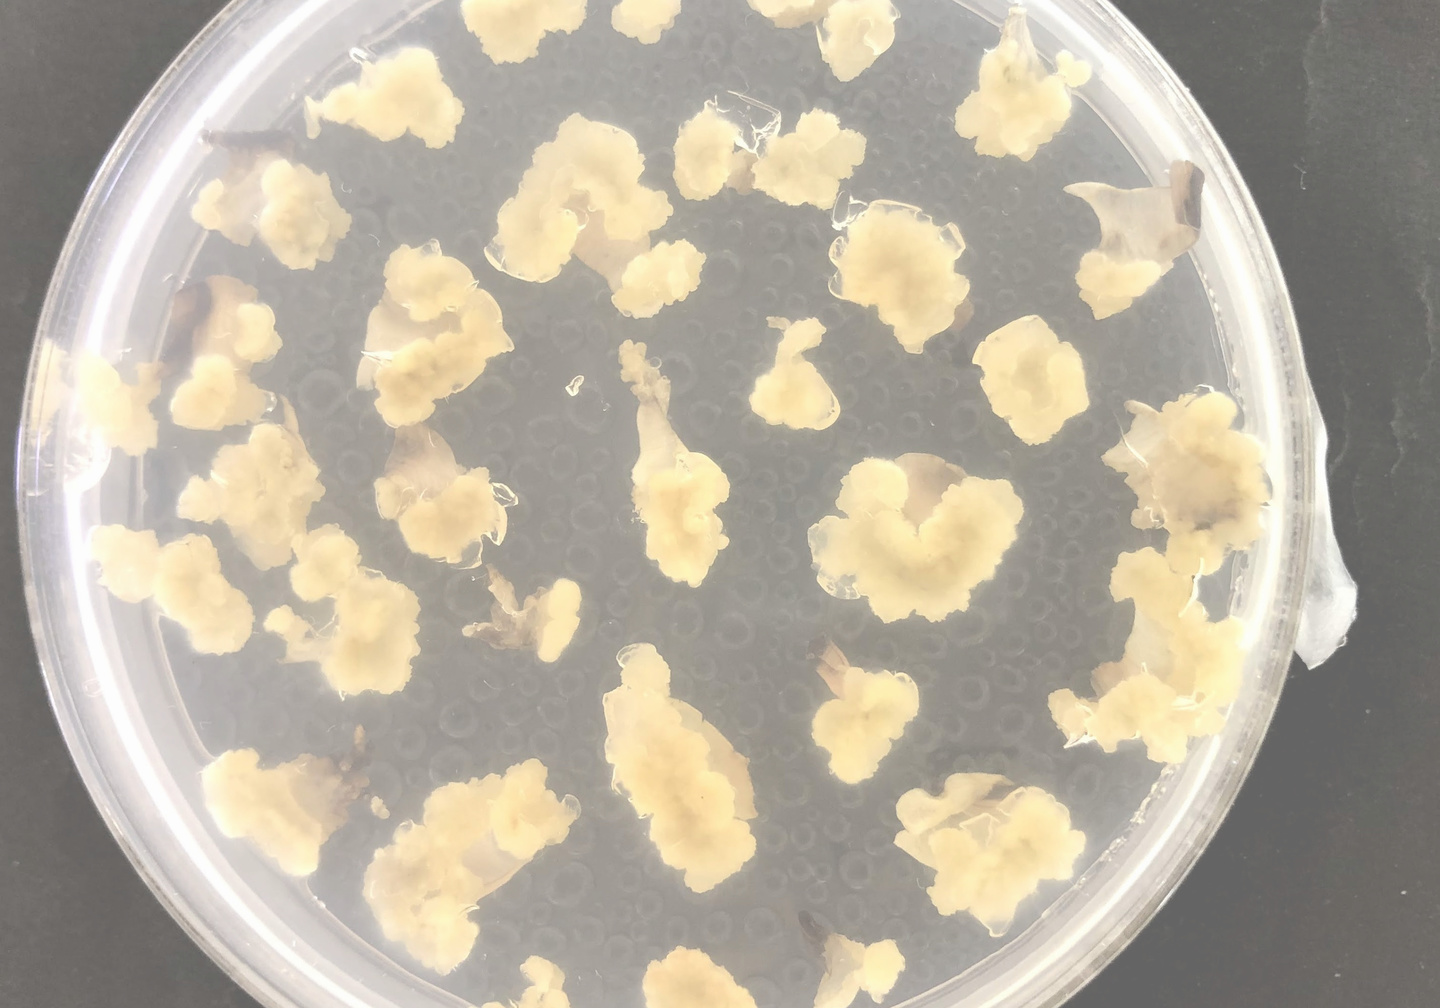

研究内容
園芸作物の高収量・高品質の持続生産を可能とする技術や品種の開発を研究しています。植物が本来必要な量以上の肥料をあげていたり、あるいは本来持っている能力を発揮できていない状態であることが考えられますので、栽培方法から目標を達成することを目指しています。
植物組織培養・遺伝子組換え技術を用いた観賞価値の高い植物の育成を行っています。組織培養技術で、植物の細胞や組織から植物体を再生させます。また、遺伝子組換え技術では、植物に特定遺伝子を導入することで、交配育種だけでは作出困難な作物をつくることができます。
近年、健康志向の高まりから「機能性成分」が注目されています。培養カルスを用いたシャクヤクの機能性成分向上や遺伝子導入によるキュウリ、ハツカダイコンなどの機能性成分蓄積を研究しています。機能性成分や抗酸化能を豊富に含んだ植物を育成し、人々の健康に貢献します。